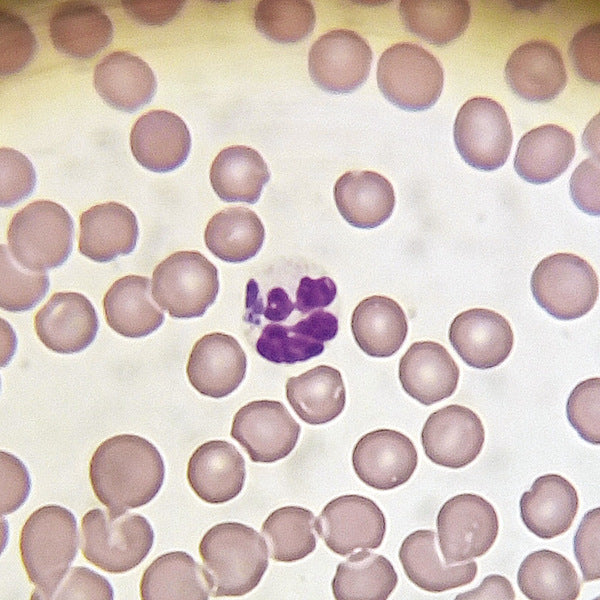

Zobacz nasze aktualne szkolenia i konferencje
-

Anestezjologia
Vet Pro Akademia zaprasza lekarzy weterynarii, którzy chcą pogłębiać swoją wiedzę i...
-

Endoskopia
Vet Pro Akademia zaprasza lekarzy weterynarii na specjalistyczne szkolenia z zakresu endoskopii,...
-

Medycyna Drobnych Ssaków
Vet Pro Akademia to kompleksowa oferta wydarzeń edukacyjnych dla lekarzy weterynarii, którzy...
-

Okulistyka
Vet Pro Akademia oferuje szkolenia z okulistyki weterynaryjnej, które pozwalają lekarzom weterynarii...
-

Szkolenia Online
Nasze szkolenia online dostępne są na platformie vetproakademia.myvod.pl, na której można je...
-

Ultrasonografia
Vet Pro Akademia zaprasza na zaawansowane szkolenia z ultrasonografii weterynaryjnej, które oferują...
1
/
z
14